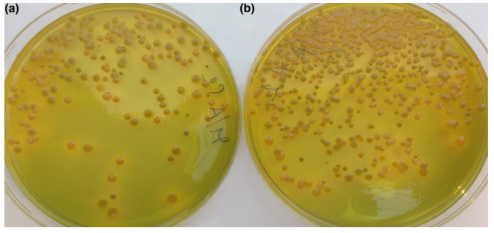
1714187472509874.png image.png

一種提高海洋弧菌分離的改良培養(yǎng)基
2024-04-27 11:12:30
一種提高海洋弧菌分離的改良培養(yǎng)基
由于海洋弧菌難以分離,生態(tài)學(xué)和生物技術(shù)研究都對(duì)它們產(chǎn)生了極大的興趣。在檢測(cè)食源性致病性物種方面已經(jīng)作出了許多研究,但關(guān)于標(biāo)準(zhǔn)培養(yǎng)基對(duì)環(huán)境弧菌的性能,我們知之甚少。
為此推薦本篇文章與大家一起學(xué)習(xí),希望能對(duì)大家有所幫助。


文提出了一種改良的TCBS作為分離培養(yǎng)基,根據(jù)海洋弧菌需求進(jìn)行調(diào)整,與標(biāo)準(zhǔn)培養(yǎng)基相比,大大提高了海洋弧菌在稀釋后于平板上的回收率。
內(nèi)容
1.摘要
TCBS瓊脂是最早用于分離和純化弧菌的選擇性培養(yǎng)基之一,并且仍然被廣泛使用。TCBS已被廣泛用于分離來自臨床標(biāo)本和食物,以及水生環(huán)境中的致病弧菌(霍亂弧菌,副溶血性弧菌,創(chuàng)傷弧菌)。此外,它還被作為所有弧菌(霍利斯弧菌和麥?zhǔn)?/span>弧菌除外)的分離和計(jì)數(shù)培養(yǎng)基。
這種培養(yǎng)基可以根據(jù)蔗糖的發(fā)酵能力來區(qū)分不同的弧菌種類,如霍亂弧菌、溶藻弧菌、哈維氏弧菌產(chǎn)生黃色菌落;相反,不發(fā)酵蔗糖的,如創(chuàng)傷弧菌和副溶血弧菌,產(chǎn)生綠色菌落。 盡管對(duì)弧菌具有選擇性,但其他屬如葡萄球菌屬、黃桿菌屬、假交替單胞菌屬和瓦氏菌也可以在TCBS上生長(zhǎng),但由于其獨(dú)特的表型,它們的菌落可以與弧菌區(qū)分開來。
對(duì)于海洋弧菌,TCBS培養(yǎng)基實(shí)際上不能被認(rèn)為完全適合海洋弧菌的分離。為此提出了一種改良的TCBS,以確保海洋弧菌在瓊脂平板上的最大回收率。改良的TCBS可以恢復(fù)其他未檢測(cè)到的弧菌,其中一些可以產(chǎn)生有生物技術(shù)價(jià)值的酶,從而擴(kuò)大潛在的新弧菌類群的分離能力。此外,報(bào)道了一種新設(shè)計(jì)的弧菌特異性PCR引物對(duì),靶向獨(dú)特的rpoD序列,有助于快速確認(rèn)分離菌作為弧菌成員和隨后的遺傳分析。
2.結(jié)果與討論
改良培養(yǎng)基的測(cè)試
將TCBS(標(biāo)準(zhǔn)培養(yǎng)基)的弧菌菌落產(chǎn)量與各種改良培養(yǎng)基(即mTCBS,mTCBS-2,mTCBS-aSW,TCBS-S和TCBS + MB)進(jìn)行了比較,與TCBS相比,它們都具有更高的離子強(qiáng)度。
除TCBS-S以外,與標(biāo)準(zhǔn)培養(yǎng)基相比,觀察到弧菌菌落數(shù)量平均增加兩倍(圖1和圖2)。用NaCl補(bǔ)充TCBS并沒有導(dǎo)致所有其他配方計(jì)數(shù)增加,因此表明其他配方的回收率主要來自于總體鹽含量,而不是離子強(qiáng)度本身。
略微降低鹽含量,用mTCBS或mTCBS-aSW替換TCBS-2被證明是有益的,因?yàn)樗纳屏司浯笮?,而沒有降低改良培養(yǎng)基相對(duì)于標(biāo)準(zhǔn)TCBS的優(yōu)勢(shì),可能是因?yàn)檎w鹽濃度更平衡。TCBS + MB生長(zhǎng)最茂盛,導(dǎo)致非常大的菌落,可能是因?yàn)闋I(yíng)養(yǎng)濃度要高得多,再加上平衡的鹽混合物(數(shù)據(jù)未顯示)。
FIGURE 1?Improved plate count on mTCBS. Comparison of Vibrio spp. plate counts of a dilution from a fish buccal swab. (a) Colonies on TCBS(standard medium). (b) Colonies onto mTCBS (modified medium)

FIGURE 2?Comparison of Vibrio recovery with different media. Vibrio spp. colony yield from three randomly selected fish buccal swabs plated on TCBS and mTCBS
改良培養(yǎng)基可提高細(xì)胞適應(yīng)性和存活率
通過比較標(biāo)準(zhǔn)培養(yǎng)基和改良培養(yǎng)基獲得的結(jié)果促使我們研究哪些弧菌可能無法在標(biāo)準(zhǔn)培養(yǎng)基上生長(zhǎng)。為此選擇了顯示最相關(guān)計(jì)數(shù)差異的瓊脂平板進(jìn)行進(jìn)一步的調(diào)查。特別是,在mTCBS上挑取90個(gè)單菌落同時(shí)接種在TCBS和 mTCBS 上,以確定導(dǎo)致這種平板計(jì)數(shù)差異的細(xì)菌。出乎意料的是,90株分離株中87株在TCBS和mTCBS上生長(zhǎng),然而其中只有大約50%(對(duì)應(yīng)于CFUTCBS/CFUmTCBS)被預(yù)計(jì)會(huì)生長(zhǎng)。據(jù)此推測(cè),在TCBS上分析天然樣品時(shí),菌落回收率較低,這可能反映了某些分離株的大多數(shù)細(xì)胞對(duì)選擇性培養(yǎng)基的適應(yīng)性較差,而不是完全無法生長(zhǎng)。
為了研究這種可能性,將 87 個(gè)分離株在海生菌肉湯(作為非選擇性培養(yǎng)基)中培養(yǎng),適當(dāng)稀釋,并接種到海生菌瓊脂(MA,作為陽性對(duì)照)、TCBS 和 mTCBS 平板上。
在 MA 和 mTCBS 上,觀察到相當(dāng)?shù)纳L(zhǎng),所有位點(diǎn)都顯示匯合生長(zhǎng),而在 TCBS 上,90株檢測(cè)分離株中的57株只產(chǎn)生了一些大小不同的菌落(大多數(shù)非常?。?,而在較高稀釋度下未生長(zhǎng)落,從而支持我們的假設(shè)。
為了排除這種結(jié)果可能是由于遺傳異質(zhì)性,從TCBS上獲得的小菌落和大菌落都被分離出來,在MB中生長(zhǎng)(以排除任何選擇),并再次測(cè)試。菌落大小被證明不是固有特征,因?yàn)闊o論起始菌落的大小如何,在 mTCBS 和 MA 上都獲得了正常和均勻大小的菌落;然而,在TCBS上再次觀察到低回收率和菌落大小異質(zhì)性。這些結(jié)果支持了細(xì)胞對(duì) TCBS 適應(yīng)率低的假設(shè),表明在TCBS上觀察到的菌落大小減少可能與少數(shù)單細(xì)胞對(duì)培養(yǎng)基的晚期增加相對(duì)應(yīng),導(dǎo)致增長(zhǎng)延遲。綜合考慮這些觀察結(jié)果,可以解釋mTCBS與TCBS的回收能力不同。
弧菌鑒定
所有在TCBS上生長(zhǎng)的弧菌分離株根據(jù)核糖體基因間隔模式進(jìn)行分組,并通過16S rDNA PCR擴(kuò)增和測(cè)序選擇每個(gè)分離株(共4個(gè),即VD、VL、VN、VO)進(jìn)行分子鑒定。
BLAST分析將VD和VN序列分配給得分相同的巨型弧菌和牡蠣弧菌;VN 和 VO 被分配到卡那羅弧菌。
分離株的蛋白水解活性
為了檢測(cè)和表征環(huán)境分離物的蛋白水解活性,包括分子大小分布,通過電泳法對(duì)鑒定的細(xì)菌進(jìn)行電泳分離后的明膠酶活性篩選。所有分離株,包括4個(gè)特征分離株,均表現(xiàn)出不同的分泌蛋白水解酶模式,分子量富集于40 KDa以下(圖3)。這些結(jié)果表明,它們具有作為低分子量分泌蛋白酶來源的應(yīng)用潛力,進(jìn)一步的功能分析表明,即使在惡劣的條件和低溫下,絲氨酸蛋白酶和金屬蛋白酶也具有很高的活性(數(shù)據(jù)未顯示)。低分子量酶,以及那些在極端條件下表現(xiàn)出高穩(wěn)定性和活性的酶,因其潛在的生物技術(shù)應(yīng)用而特別有吸引力。

FIGURE 3?Secreted proteases activity of isolates. Aliquots of culture medium after overnight growth ofrepresentative isolates were analyzed to detect gelatinolytic activity of secreted proteases. On the left, positions of molecular weight marker bands are reported. Lane 1–12: Vibrio isolates from mTCBS
討論
本文報(bào)道的數(shù)據(jù)清楚地表明,一些海洋弧菌無法在選擇性培養(yǎng)基(如標(biāo)準(zhǔn)TCBS瓊脂)上生長(zhǎng),并且它們需要調(diào)整培養(yǎng)基組成才能成功分離。事實(shí)上,使用改良的TCBS培養(yǎng)基大大提高了這些微生物的整體回收率,在大量的平板上數(shù)量增加,應(yīng)考慮使用調(diào)整后的培養(yǎng)基,以更好地滿足細(xì)菌的生理要求。
改良培養(yǎng)基使我們能夠分離出原本未被發(fā)現(xiàn)的弧菌,這些弧菌被證明可以產(chǎn)生具有生物技術(shù)吸引力的低分子量酶,這突出了如何提高分離能力,極大地有助于擴(kuò)大從自然環(huán)境中提取合適酶的產(chǎn)量。為此我們強(qiáng)烈建議在海洋弧菌的任何分離或計(jì)數(shù)時(shí)使用改良的TCBS。


0513-85596088





